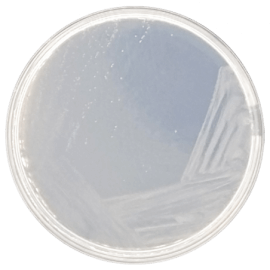
main product photo

Close
CZAPEK DOX AGAR MODIFIED 500 grams/bottle
SKU
CDL/1015
Brand
CONDALAB
Pre-order (Deliver in 8 to 12 weeks)
Czapek-Dox Modified Agar is commonly used for the cultivation of fungi and chlamydospore formation by C. albicans. For the cultivation of acidophilic organisms, such as yeasts, the acidity of the medium may be increased. It is also used for taxonomic studies of Aspergillus, Penicillium and Actinomycetes.
Czapek-Dox Modified Agar is a semi-synthetic medium which contains sodium nitrate as a sole source of nitrogen. It has the advantage of a chemically defined formulation, which has been modified in its original formula by substituting magnesium sulfate and potassium phosphate with the magnesium glycerophosphate in this formula to prevent the precipitation of magnesium phosphate. The medium is prepared with inorganic nitrogen sources and chemically defined carbon sources only.
Sucrose is the sole fermentable carbohydrate providing carbon and energy. Sodium nitrate is the sole nitrogen source. Potassium salts act as a buffer system. Potassium chloride contains essential ions. Magnesium glycerophosphate and ferrous sulfate are sources of cations. Bacteriological agar is the solidifying agent.
Czapek-Dox Modified Agar is commonly used for the cultivation of fungi and chlamydospore formation by C. albicans. For the cultivation of acidophilic organisms, such as yeasts, the acidity of the medium may be increased. It is also used for taxonomic studies of Aspergillus, Penicillium and Actinomycetes.
Czapek-Dox Modified Agar is a semi-synthetic medium which contains sodium nitrate as a sole source of nitrogen. It has the advantage of a chemically defined formulation, which has been modified in its original formula by substituting magnesium sulfate and potassium phosphate with the magnesium glycerophosphate in this formula to prevent the precipitation of magnesium phosphate. The medium is prepared with inorganic nitrogen sources and chemically defined carbon sources only.
Sucrose is the sole fermentable carbohydrate providing carbon and energy. Sodium nitrate is the sole nitrogen source. Potassium salts act as a buffer system. Potassium chloride contains essential ions. Magnesium glycerophosphate and ferrous sulfate are sources of cations. Bacteriological agar is the solidifying agent.
| Brand | CONDALAB |
|---|
Write Your Own Review

Validate your login